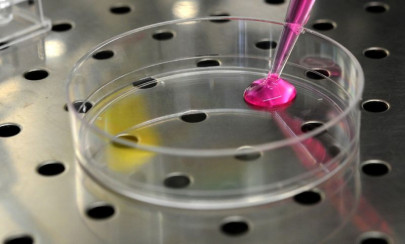
genetic testing often overlooked for cancer risk women study

cancer
More News
-
China probes academic fraud by cancer researchers
Researchers involved in the mass retraction have had their projects and funding suspended.
-
New approaches aim to calm anxiety in cancer patients
About 50 per cent of all cancer survivors report moderate to high fear of recurrence
-
Researchers find strong link between high platelets count and cancer
Researchers noted cancer to be more common in those who have the condition for a long time
-
Husband reveals why he slept in same room as wife's dead body for six days
Death is such a taboo in our society that no one wants to talk about it
-
Scientists engineer a blood test to detect cancer relapse
'We can identify patients to treat even if they have no clinical signs of disease'
-
Crowdfunding cancer treatment helping Kashmiris in held valley
Sana’s sister appealed on Facebook and the family was able to raise $40,000 in one month
-
Bollywood actor Vinod Khanna responds to treatments positively and is stable
Previously, rumour had it that Vinod had been diagnosed with bladder cancer
-
Veteran Indian actor Vinod Khanna is reportedly suffering from cancer
The news came after an image of the frail looking star went viral on social media
-
Cancer-stricken: Veteran TV actress Naila Jaffri 'requires financial support'
Her body is not responding, says playwright Ali Moeen
-
World's most expensive burger sells for $10,000 in Dubai
The $10,000 burger was auctioned to raise money for a charity
-
Swift childhood cancer deaths more common than thought: study
The SEER database showed that 6.2 per cent of children with acute myeloid leukemia died early
-
Faisalabad kid becomes CTO for a day
9-year-old Abdullah Noor is suffering from blood cancer
-
‘I am an extraordinary 21-year-old’: LUMS student’s final post about battle with cancer
Mahnoor Shabir passed away on Monday after a hard-fought battle for her life
-
Genetic testing often overlooked for cancer risk women: study
About 56 per cent of those who were not tested said it was because their physicians had not recommended it
-
This World Cancer Day, let's talk about child patients
Every time we hear the word “cancer”, our minds conjure up images of grown men; therein lies the problem
-
Software as good as doctors at diagnosing skin cancer
Image-scanning software developed at Stanford University can distinguish deadly skin cancers from benign
-
Does depression boost the risk of cancer death?
Distress might be a consequence of the early stages of the malignancy rather than a potential predictor
-
Browned bread, chips 'may' cause cancer, UK officials warn
Research undertaken on animals has revealed that the chemical is toxic to DNA and causes cancer
-
Carberry set for return after cancer operation
Former England batsman was diagnosed six months ago
-
Sick Dutch boy's nail-varnish dare nets over 2.5 mn euros
Tijn's family learned only last week that a course of chemotherapy had failed to reduce the size of his cancer
-
PK-661: Aisha Usman – girl who wanted to cure cancer
Family and friends recall life of brilliant student who died in Havelian crash
-
Magic-mushroom compound boosts cancer patients' mindset
Experts warned that some people should not be considered candidates for psilocybin therapy
-
Singer Michael Buble says 3-year-old son has cancer
'I have put our careers on hold in order to devote all our time and attention to helping Noah get well'
-
Val Kilmer denies he is suffering from cancer
"I love Michael Douglas but he is misinformed. The last time I spoke to him was almost two years ago."
-
Michael Douglas reveals Val Kilmer has oral cancer
Reports revealed that Kilmer’s health did not look well.
-
The will to survive; ‘Let our stories become your strength’
Women come together to discuss taboos and myths behind breast cancer
-
Motorcycle diaries: Bikers team up against prostrate cancer
Enthusiasts take a ride through streets on revamped vintage scooters
-
Gone too soon: The angel rests in the heavens
Rehan Rind dies after a brief battle with blood cancer at a private hospital
-
Scientists find cancer in million-year-old fossil
Until this discovery, the oldest known tumor in a human body was only 120,000 years old
-
Scientists hunt 'anti-evolution' drugs in new cancer fight
Like bacteria evolve resistance to antibiotics, cancer cells also change to evade the medicines used to fight them
-
Former England batsman Carberry diagnosed with cancer
35-year-old, who played the last of his six Tests in 2014, consulted a specialist on Tuesday
-
False hope? China's military hospitals offer illegal experimental cures
Wei died at the age of 21, and the outcry his case provoked has thrown a spotlight on hundreds of hospitals
-
Researchers discover way to treat brain cancer more effectively
Scientists have been researching ways to bypass blood-brain barrier for over 50 years
-
Very hot drinks 'probably' cause cancer: UN body
IARC has reviewed more than 1,000 scientific studies on the possible cancer-causing properties of coffee
-
Microsoft finds cancer clues in search queries
By analysing queries, scientists may be able to identify internet users who are suffering from pancreatic cancer
-
Promising drugs stoke talk of eventual cancer "cure"
Immunotherapy Keytruda is a new type of drug that enlists the body's defenses in the fight to beat cancer.
-
Mobile phone usage linked to cancer, reveals groundbreaking study
Study is believed to be one of the largest and most detailed analysis of mobile phones and cancers
-
K-P govt to offer free treatment for all kinds of cancer
Rs1.945b allocated for purpose, programme to continue till 2019
-
12 ways to staying cancer-free
According to the study, tobacco is a major cause of cancer
-
Uganda's only cancer treatment machine breaks, patients left waiting
The device, bought in 1995 and sited at the main Mulago referral hospital, stopped working early in April
-
Tech billionaire donates $250 mn for cancer 'moonshot'
Almost 600,000 Americans are expected to die of cancer in 2016, according to the American Cancer Society
-
Medical advice: ‘A healthy lifestyle can prevent cancer’
Dr Kulsoom Ghias stresses the need for increased research on the disease
-
‘There’s always light at the end of the tunnel’
Cancer patients and survivors attend AKUH’s annual children’s oncology haematology party
-
Cancer kills 12,000 Pakistanis annually
Some 150,000 people diagnosed with the disease each year, Tarar says
-
Are cancer screenings a gamble?
The holistic medical philosophy of improvement of a patient’s life requires case-wise consideration.
-
Delhi govt asks Gauri, Kajol to stop husbands from endorsing cancer-causing brand
If only SRK, Ajay Devgan and Arbaaz Khan listen to their wives!
-
Study shows low-dose chemo keeps cancer under control
The new approach delivers continuous low-dose chemotherapy that stabilizes the tumor
-
New cancer treatment boosts morale of terminally ill patients
The trial study utilised white blood cells from patients with leukaemia to come up with a treatment for cancer
-
Men face higher risk of cancers linked to oral sex
Middle aged white men are at particularly high risk compared to other races
-
Lahore’s Children Hospital to perform first ever bone marrow transplant in July
Medical director of Karachi-based NIBD will coordinate with institute’s management to finalise arrangements